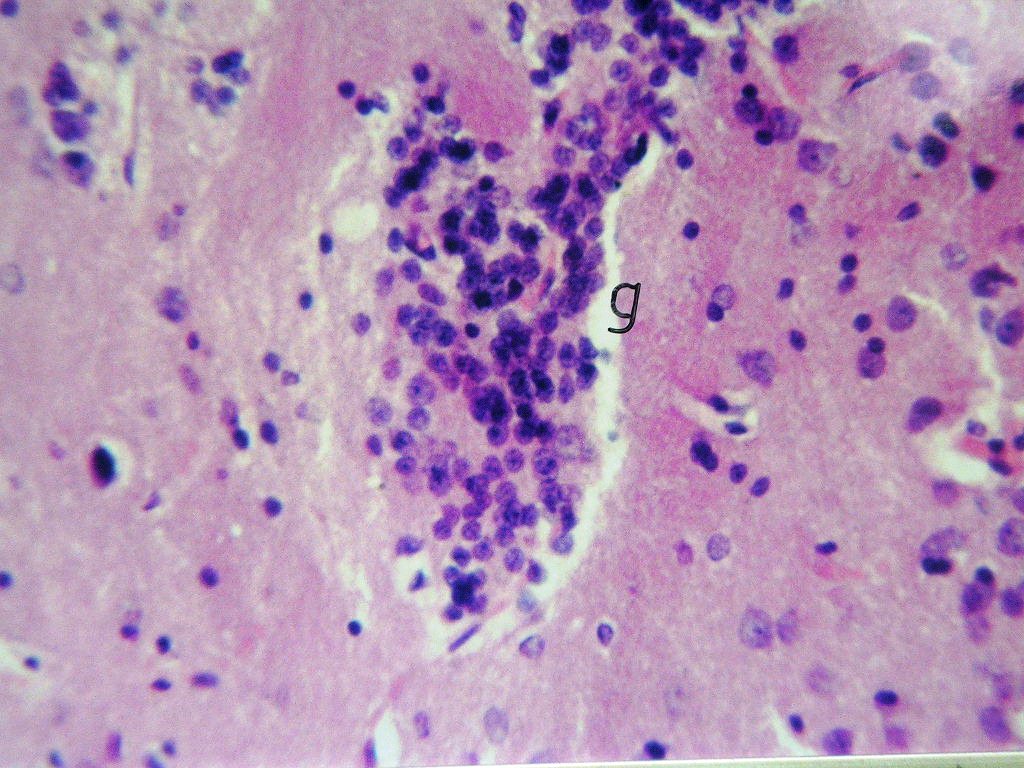

1Department of Zoology -Girl's college for Arts, Science and Education, Ain Shams University, 2Enviromental & Occupational Medicine, National Research Centre, Cairo, Egypt, 3Department of Hormones, National Research Centre, Cairo, Egypt.
Email: hanaaomr@yahoo.com
Received: 04 Oct 2014 Revised and Accepted: 05 Nov 2014
ABSTRACT
Objective: This study end to investigate the efficacy of α-chymotrypcin in management of Alzheimer's disease (AD) in the experimental model.
Methods: Sixty adult female albino rats were divided into four groups, (1) normal control group, (2) rats underwent surgery to remove ovaries (Ovex group), (3) Ovx rats received aluminum chloride to induced AD (AD group) and (4) AD rats treated with α-chymotrypcin (α-ch group).
Results: In comparison with the normal control group, the Ovx group recorded significant increase in the brain level of transforming growth factor-β, while the brain levels of brain derived neurotrophic factor and vascular endothelial growth factor were significantly decreased. Similarly, AD group displayed the same effect versus the Ovex group. Treatment of AD group with α-chymotrypcin resulted in significant improvement in the biochemical parameters as compared to untreated AD group. These results were confirmed by the histological examination of brain tissue. Conclusion: The current study suggests that α-chymotrypcin has a potent role in restraining AD due to its proteolytic and anti-inflammatory activity.
Keywords: Alzheimer’s disease, α-chymotrypcin, Proteolytic activity, Anti-inflammatory property.
INTRODUCTION
Alzheimer's disease (AD) is the most common form of dementia in elderly people worldwide. It is reported that the number of affected people is expected to double in the next 20 years, and 85 people will be affected by 2050 [1,2]. This chronic, degenerative, and terminal disease was first described by German psychiatrist Alois Alzheimer in 1906 and was named after him [3,4].
Alzheimer’s disease is characterized mainly by progressive neuronal cell dysfunction and the formation of amyloid plaques in the brain. The major constituent of AD plaques is the amyloid β-peptide (Aβ), which is a product cleaved from the membrane-bound amyloid precursor protein (APP) by β- and γ-secretases [5,6].
Although the development of AD is incompletely understood, amyloid-β (Aβ), a 39–43 amino acid peptide, is thought by many, though not all, to play a major role in disease pathogenesis. The neurotoxicity of Aβ may result from the formation of protease-resistant oligomeric and fibrillar forms of Aβ, and thus,the blocking of Aβ aggregation may provide a valuable therapeutic approach [7].
The main risk factors for AD are age, age related diseases such as cardiovascular disease, diabetes and obesity, low educational levels, head trauma and exposure to heavy metals such as aluminum, cupper, iron and zinc[8,9,10,11,12]. During the last decade, an abundance of research has continued to link aluminum (Al) with AD [13].
Aluminum (Al) is a common metal in the environment and one of the most abundant one in the terrestrial crust. Al is liberated in the environment by natural processes of soil erosion, volcanic eruptions and anthropogenic actions [14]. Aluminum utensils are widely used in the world, especially in the developing countries [15]. This may increase the aluminum content, particularly in the food that is salty, acidic or alkaline[16]. Also, aluminum is widely used in food additives and toothpaste [17].
Excessive Al intake leads to memory impairments [18], deposition of amyloid protein in central nerve cells and over expression of APP [19]. Researches show that Al-induced neurotoxicity is associated with apoptosis [20,21] and oxidative stress [21-23].
Anti-inflammatory refers to the property of a substance or treatment that reduces inflammation. Anti-inflammatory drugs make up about half of analgesics, remedying pain by reducing inflammation as opposed to opioids which affect the brain. Some clinical studies have suggested that a prolonged intake of certain anti-inflammatory (non-steroid) drugs may have a positive effect on AD. By contrast; the existing anti-inflammatory treatment trials for Alzheimer’s disease have typically shown little to no effect on halting or reversing this disorder [24].
Nonsteroidal anti-inflammatory drugs, usually abbreviated to NSAIDs are drugs with analgesic and antipyretic (fever-reducing) effects [25]. NSAIDs like ibuprofen and naproxen are used to protect against AD [26].
α-Chymotrypcin is secreted in small intestine as trypsin and chemotrypsin, they have an ability to convert protein molecules into amino acids, dipeptides, and tripeptides. The dipeptides and tripeptides are converted to amino acids by other enzymes. Once the amino acids are free, they can move into the blood stream and circulate throughout the body [27].
α-chymotrypsin possesses potent anti-inflammatory properties that enable to hasten the resorption of inflammatory oedema as well as post-operative and post-traumatic haematoma and oedema [28].
So, the present study was under taken to investigate the effect of α-chymotrypsin (α-ch) for management of AD in the experimental model.
MATERIALS AND METHODS
Chemicals and Drug
Experimental Animals
In the present study, the adult female rats were first ovaryctomized by surgical operation to remove the protective effect of estrogen against the onset and progression of AD as suggested by Valles et al. [29].
Adult female Sprague Dawley rats (130 ± ) were obtained from the Animal House Colony of the National Research Centre. They were kept in plastic cages at room temperature (25±2˚C) and humidity (55%) under a 12 hrs dark-light cycle. All animals were accommodated with laboratory conditions for at least two weeks before starting the experiment and they were maintained under the same conditions all over the experiment. Diet and water were allowed ad libitum. All animals received human care in compliance with the guidelines of the Ethical Committee of Medical Research of the National Research Centre, Cairo, Egypt.
Experimental Design
Animals were randomly divided into four groups (15 rats for each). The first group received saline solution orally daily for two months and served as normal control group (con group). The second group underwent surgery to remove ovaries (ovx control group); the third group underwent surgery to remove ovaries and received orally aluminum chloride in a dose of 17 mg/kg [30], daily for two months to induce AD (AD group). The fourth group was underwent surgery to remove ovaries and received orally aluminum chloride in a dose of 17 mg/kg, daily for two months then treated with α-chymotrypcin, in a dose of (8.1 unit/rat/day) intramuscular, which is equivalent to the recommended human dose [31] for three months (α-ch group).
Samples Collection
At the end of the experimental period, the animals were sacrificed and the whole brain of each animal was rapidly removed, thoroughly washed with isotonic saline, dried on filter paper and then weighed. One half of each brain was homogenized immediately to give 10% (w/v) homogenate in ice-cold medium contains Tris-Hcl (pH 7.4) and sucrose [32]. The homogenate was centrifuged at 800 xg for 10 min at 4 ºC. The supernatant (10%) was separated for biochemical analysis. The second half of each brain was fixed in 10% buffered formalin and embedded into paraffin blocks. Histological examination was carried out on 5 µ m-thick, hematoxylin–eosin (H&E) stained brain sections [33].
Biochemical Analysis
Quantitative estimation of total protein concentration in the brain homogenate was carried out according to the method of Lowry et al. [34]. Brain transforming growth factor –beta level (TGF-β1) was determined by ELISA technique [35] using a kit purchased from Drug-diagnostics Co., Germany. Brain derived neurotrophic factor (BDNF) was estimated by ELISA technique [36] using kit purchased from RayBiotech Co., USA. Brain vascular endothelial growth factor (VEGF) was estimated by ELISA procedure [37] using a kit purchased from Invitrogen Co., CAMARILLO, and VENTURA, California, USA.
Statistical analysis
In the present study, all results were expressed as mean ±S. E of the mean. Statistical Package for the Social Sciences (SPSS) program, version 11.0 was used to compare significance between each two groups. Difference was considered significant when P≤0.05. Difference was considered significant when P value was > 0.05. Percentage difference representing the percent of variation with respect to the corresponding control group was also calculated using the following formula.

RESULTS
The results in table (1) showed the effect of α-chymotrypcin treatment on brain growth factors of AD rats. In comparison with normal control group, there was significant increase in the brain level of TGF-β (25.96 %) accompanied with significant decreases in BDNF level (-31.25%) and VEGF level (-19.96%) in the ovx group. Also, AD rats recorded a significant elevation in the levels TGF-β (9.99%), but recorded significant decreases in the brain levels of BDNF (-18.18%) and VEGF (-37.78%) as compared to the ovx group. On the other hand, treatment of AD group with α-chymotrypcin caused a significant reduction in the levels of TGF-β (-25.97%) accompanied with significant elevations in the brain levels of BDNF (44.44%) and VEGF (53.32%), compared to AD group.
Table 1: The effect of α-chymotrypcin treatment on growth factors of brain AD rats.
| Parameters
Groups |
TGF-β
Pg/mg protein |
BDNF
ng/mg protein |
VEGF
Pg/mg protein |
| Normal control
group |
779.20±1.25 | 0.32±0.008 | 3593.11±39.50 |
| OVX
group |
981.51±1.49a
D (25.96%) |
0.22±0.003a
D (-31.25%) |
2876.95±101.26a
D (-19.96%) |
| AD
group |
1079.55±2.17 b
E (9.99%) |
0.18±0.003 b
E (-18.18%) |
1790.18±244.01b
E (-37.78%) |
| α-ch group | 799.22±1.25 c
F (-25.97%) |
0.26±0.003 c
F (44.44%) |
2744.78±48.02c
F (53.32%) |
The mean difference is significant at the P≤ 0.05, a =compared to the normal control group.
b =compared to the OVX control group, c = compared to the AD group.
Histological Investigation
Fig (1): Micrograph of brain section of normal control rat showing normal morphological structure of the hippocampus (H& E X40). Fig (2): Micrograph of brain section of ovariectomized control rats showing normal morphological structure of the hippocampus (H& E X 40). Fig (3): Micrograph of brain section of Al-intoxicated ovariectomized (AD group) rats showing various sizes of amyloid plaques formation (arrow) in the cerebral cortex and hippocampus (H& E X 40). Fig (4): Micrograph of brain section of AD rats treated with α-chymotrypcin in a dose of (8.1 unit/rat/day) showed the presence of focal gliosis in the cerebrum and disappearance of most of amyloid plaques.

Fig. 1: Micrograph of brain section of normal control rat showing normal morphological structure of the hippocampus (H& E X40)
Fig. 2: Micrograph of brain section of ovariectomized control rat showing normal morphological structure of the hippocampus
(H& E X 40).

Fig. 3: Micrograph of brain section of Al-intoxicated ovariectomized (AD group) rat showing various sizes of amyloid plaques formation (arrow) in the cerebral cortex and hippocampus (H& E X 40).
Fig. 4: Micrograph of brain Section of AD rats treated with α-chymotrypcin in a dose of (8.1 unit/rat/day) showed the presence of focal gliosis in the cerebrum associated with the disappearance of most of amyloid plaques.
DISCUSSION
Alzheimer's disease (AD) is an age-dependent neurodegenerative disease characterized by progressive loss of cognitive functions and pathological changes in the brain, such as extracellular aggregates of beta-amyloid and hyperphosphorylation of tau proteins. Cholinergic neurons have been found to degenerate in AD and the lack of cortical acetylcholine correlates with the marked cognitive decline observed in AD [38].
TGF-β levels appear to increase in response to several factors, including high glucose, oxidative stress, advanced glycation end product (AGE) and high lipid levels [39]. TGF-β1 is a multifunctional cytokine with a pivotal role in tissue injury and repair, regulating the growth and survival of neurons [40,41].
The results of the present research showed a significant increase in the brain level of TGF-β in ovx group versus the normal control group. This effect is in agreement with Choi and Song [42] who suggested that the increment in TGF-β may be associated with the increased expression of extracellular matrix proteins, such as fibronectin, and the decreased activity of metalloproteinase-2, an extracellular matrix–degrading enzyme.
Also, the data of the current research revealed that the injection of rats with AlCl3 caused a remarkable elevation in the level of TGF-β as compared to the ovx control group. This result is in agreement with the observation of Tarkowski et al. [43]. who showed an increase in TGF-β and TGF-β receptor immunoreactivity in senile plaques, neurites, neuronal neurofibrillary tangles, microglia, astrocytes and macrophages in the brains of AD patients. These authors mentioned that TGF-β is a pleiotropic cytokine, whose cellular site of synthesis and targets are widely distributed throughout the body, including the central nervous system (CNS) [43]. Also, Motta et al. [40] suggested that the deposition of Aβ in the brain tissue seems to induce a remarkable inflammatory cascade, which in turn activates the immune system leading inflammatory cytokines production. The present data are in consistent with other reports that showed elevations of TGF-β1 expression and immunoreactivity in AD patients in comparison to non-demented elderly controls [44].
The other possible explanation for the increasing TGF-β in the brain of AD group in the present study was suggested by Zetterberg et al. [45]. TGF-β1 may increase clearance of Aβ from the brain and cerebrospinal fluid (CSF) by activating microglia cells. Hence, the increased levels of TGF-β in the CNS of AD patients may actually reflect a defense mechanism against further accumulation of Aβ in the brain parenchyma, implying a dual effect of TGF-β1 in amyloid plaque metabolism and AD pathogenesis [45].
On the other hand, the treatment with α-chymotrypcin caused a marked reduction in the brain level of TGF-β. This decrease of TGF-β was proposed to be a result of the role of α –chymotrypcin in the lysis of Aβ protein which forms plaques in the brain tissue, in addition to the ability of α-chymotrypcin to reduce the inflammation in brain tissue contributed positively to the decreased brain level of TGF-β [26].
Since its discovery over 20 years ago, BDNF has been shown to play a key role in neuronal survival, in promoting neuronal regeneration following injury, regulating transmitter systems and attenuating neural-immune responses [46].
The data in the present study revealed that the ovx group recorded a significant decrease in the brain level of BDNF as compared to normal control group. This result is in agreement with Franklin and Perrot-Sinal [47] who suggested that, estrogen has a neuroprotective effect via its regulation of BDNF and ovariectomized rats display an increase in colchicine-induced apoptosis in the brain. BDNF has been linked to neurogenesis through its regulation of N-methyl-D-aspartate (NMDA) receptor activity. Low levels of BDNF as demonstrated in this study may result in decreased basal neurogenesis.
The present study recorded a significant decrease in the brain level of BDNF in AD group in comparison to the ovx control group. This decrease of BDNF was guessed to be a result of the injuries of the nerve and glial cells in the brain and this coincides with Gotohda et al. [48]. These injuries may be due to the toxicity induced by aluminum injection. Furukawa [49] reported that BDNF is not increased in the surroundings of the damaged area of the brain. Also, down regulation of proBDNF was suggested by Furukawa [49] to be an event underlying early Alzheimer’s disease. Komulainen et al. [50] reported that both the intensity of BDNF immunopositive neuronal cell bodies in hippocampus and temporal cortex appear to be decreased in AD.
On the other hand, the brain level of BDNF was increased after the treatment of AD groups with α-chymotrypcin. This increase was suggested to be a result of the ability of α-chymotrypcin to decompose the proteinouse plaques which accumulated in the brain tissue and to remove the first cause for libration of the reactive oxygen species (ROS) which caused apoptosis and injuries in the brain due to injection of aluminum chloride [21]. In addition to the ability of α-chymotrypcin to reduce the inflammation in brain tissue contributed positively to the high increase in the brain level of BDNF.
Vascular endothelial growth factor (VEGF) is a critical angiogenic factor known to be required for the normal development of the vasculature as well as for pathologic angiogenesis. VEGF exerts its effects on the vascular endothelium through binding to 2 high-affinity receptors, R1 (fms-related tryosine kinase [Flt-1]) and R2 (kinase insert domain-containing receptor/fetal liver kinase [KDR/Flk-1]). This binding, in turn, activates the intrinsic tyrosine kinase activity of their cytodomains, initiating intracellular signaling [51,52].
The present results recorded a significant decrease in the level of VEGF in brain tissue of ovx group as compared with that in the normal control group. These results agree with the results of Mekraldi et al. [53] who suggested that estrogen stimulates endothelial cell proliferation in a paracrine manner and this might help in maintaining vessel number. The significant decrease in VEGF level in ovx group may be due to a significant decrease in vessel number due to estrogen depletion. Moreover, Yu et al. [54] found that the expression of VEGF was extremely lower after ovariectomy.
AD group recorded a significant decrease in the brain VEGF level, compared to the ovx group. VEGF is a homodimeric glycoprotein which acts as a highly specific mitogen for vascular endothelial cells, being capable of inducing angiogenesis. In addition, it is a potent inducer of vascular permeability and it acts as a survival factor for the newly-formed blood vessels [55]. Aluminum has been found to cause brain damage due to its role in induction of oxidative stress and production of ROS [21]. So, aluminum might destruct the vasculature of the brain when inducing AD model. This suggestion is in agreement with the post-mortem examinations of the brains of AD patients which displayed a cerebrovascular pathology concomitant to AD pathology [43]. Also, the electron microscopy study showed that alterations of the capillaries are a common finding in AD [43, 56].
On the other hand, the treatment of AD group with α-chymotrypcin caused a significant elevation in the brain level of VEGF which may be attributed to the role of α –chymotrypcin as antioxidant agent. This suggestion is in consistent with Latha et al. [57] who stated that the treatment with enzyme preparation (trypcin and chymotrypsin) reduced tissue destruction via scavengening the free radicals in addition to its ability to promote the enzymatic and non-enzymatic antioxidants.
With respect to the microscopic examination of brain tissue of AD group, the present results suggest that the chronic exposure to Al reduces the avoidance response and increases the expression of Aβ immunoreactivity in the hippocampus. These results merging with previous studies [58,59,60] provid a direct evidence to support viewpoint that Al may be a potential contributing factor in the formation of neurofibrillary tangles and cognitive deficits in Alzheimer's disease [61].
In regard to the effect of α –chymotrypcin on the improvement of the morphological feature of brain tissue of AD group, the current results could be attributed to the role of α –chymotrypcin as an antioxidant agent to scavenge of ROS which resulted from aluminum in the brain besides its proteolytic activity to remove the most of amyloid plaques [57].
Conclusion
The present study provides clear evidence that α –chymotrypcin represents a novel approach for management of AD due to its ability to ameliorate the neurodegeneration characteristic for AD in the experimental model. This effect of α –chymotrypcin could be related to its proteolytic activity and anti-inflammatory property
CONFLICT OF INTERESTS
Declared None
REFERENCES